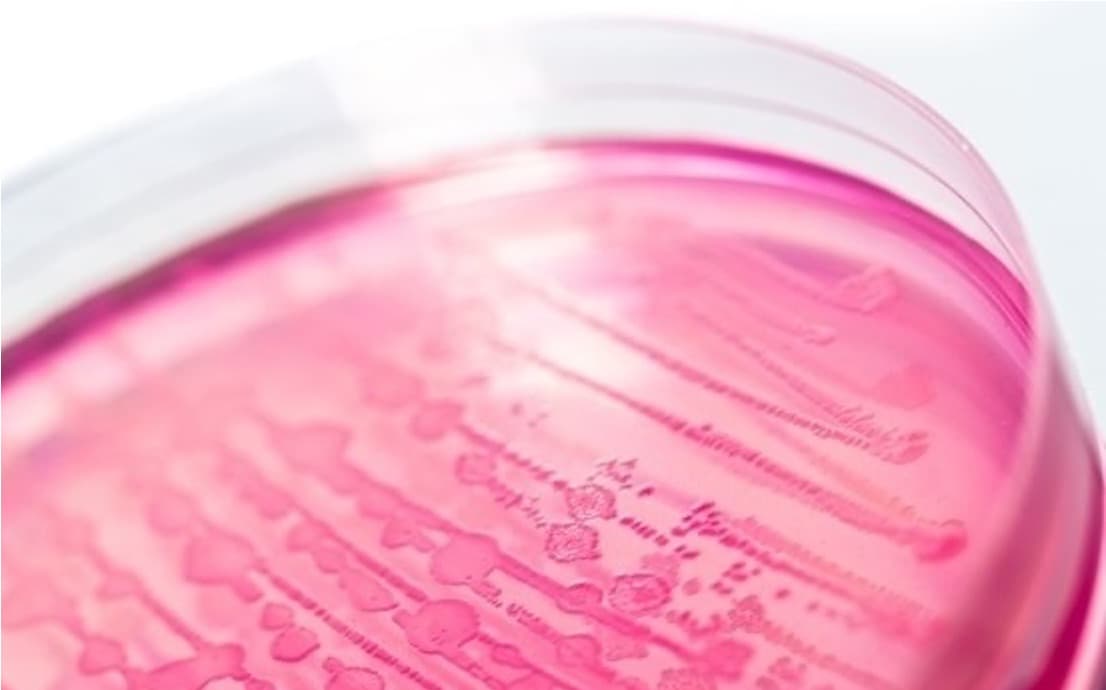
Widespread E. coli contamination found in Egyptian dairy

Sheikh Dr Sultan bin Muhammad Al Qasimi, Ruler of Sharjah, has hailed the launch of a vast dairy farm and factory capable of producing 100,000 litres of milk each day as a dream more than half a centu...Read More

In the wake of the India–New Zealand Free Trade Agreement (FTA), industry voices from New Zealand’s dairy sector are pointing to emerging opportunities for value-added exports, even as traditional bul...Read More

New Zealand’s largest dairy co-operative, Fonterra, has acknowledged the conclusion of the India–New Zealand Free Trade Agreement (FTA) but described the outcome as disappointing for dairy access, par...Read More

China will impose provisional duties of up to 42.7% on certain dairy products imported from the EU from Tuesday after concluding the first phase of an anti-subsidy investigation widely seen as retalia...Read More

New Zealand and India have concluded a Free Trade Agreement, offering New Zealanders unprecedented access to 1.4 billion Indian consumers, Trade and Investment Minister Todd McClay announced today. T...Read More

Biotechnology is no longer a laboratory concept but a concrete vector of industrial transformation. In health, its advances promise personalised treatments for complex diseases; in food, and particula...Read More

he dairy sector is showing signs of renewed strength as global consumption patterns rebound and diversified demand drivers push the category back into growth momentum, according to the latest AgProud...Read More

Emerging scientific evidence continues to highlight the protective benefits of breastfeeding, with recent findings indicating that infants who receive breast milk may have a lower risk of developing f...Read More

Lactalis, Fonterra, Unilever, and European cooperatives reshape global dairy landscape through transformational acquisitions, spin-offs, and strategic mergers totaling billions. General Mills’ $2.1 bi...Read More

The U.S. House of Representatives today passed the Whole Milk for Healthy Kids Act of 2025 by voice vote, delivering final congressional approval for legislation that will restore whole and 2% milk to...Read More

The outcome of Global Dairy Trade Event 394 held on 16 December 2025 confirms a decisive bearish turn in the global dairy commodity cycle, with the GDT Price Index falling sharply by 4.4% to an averag...Read More
Rabobank and Fonterra warn that surging Global Dairy Production across key exporters is outpacing demand, driving down commodity prices. A dramatic reversal has hit the global dairy market, with Milk...Read More